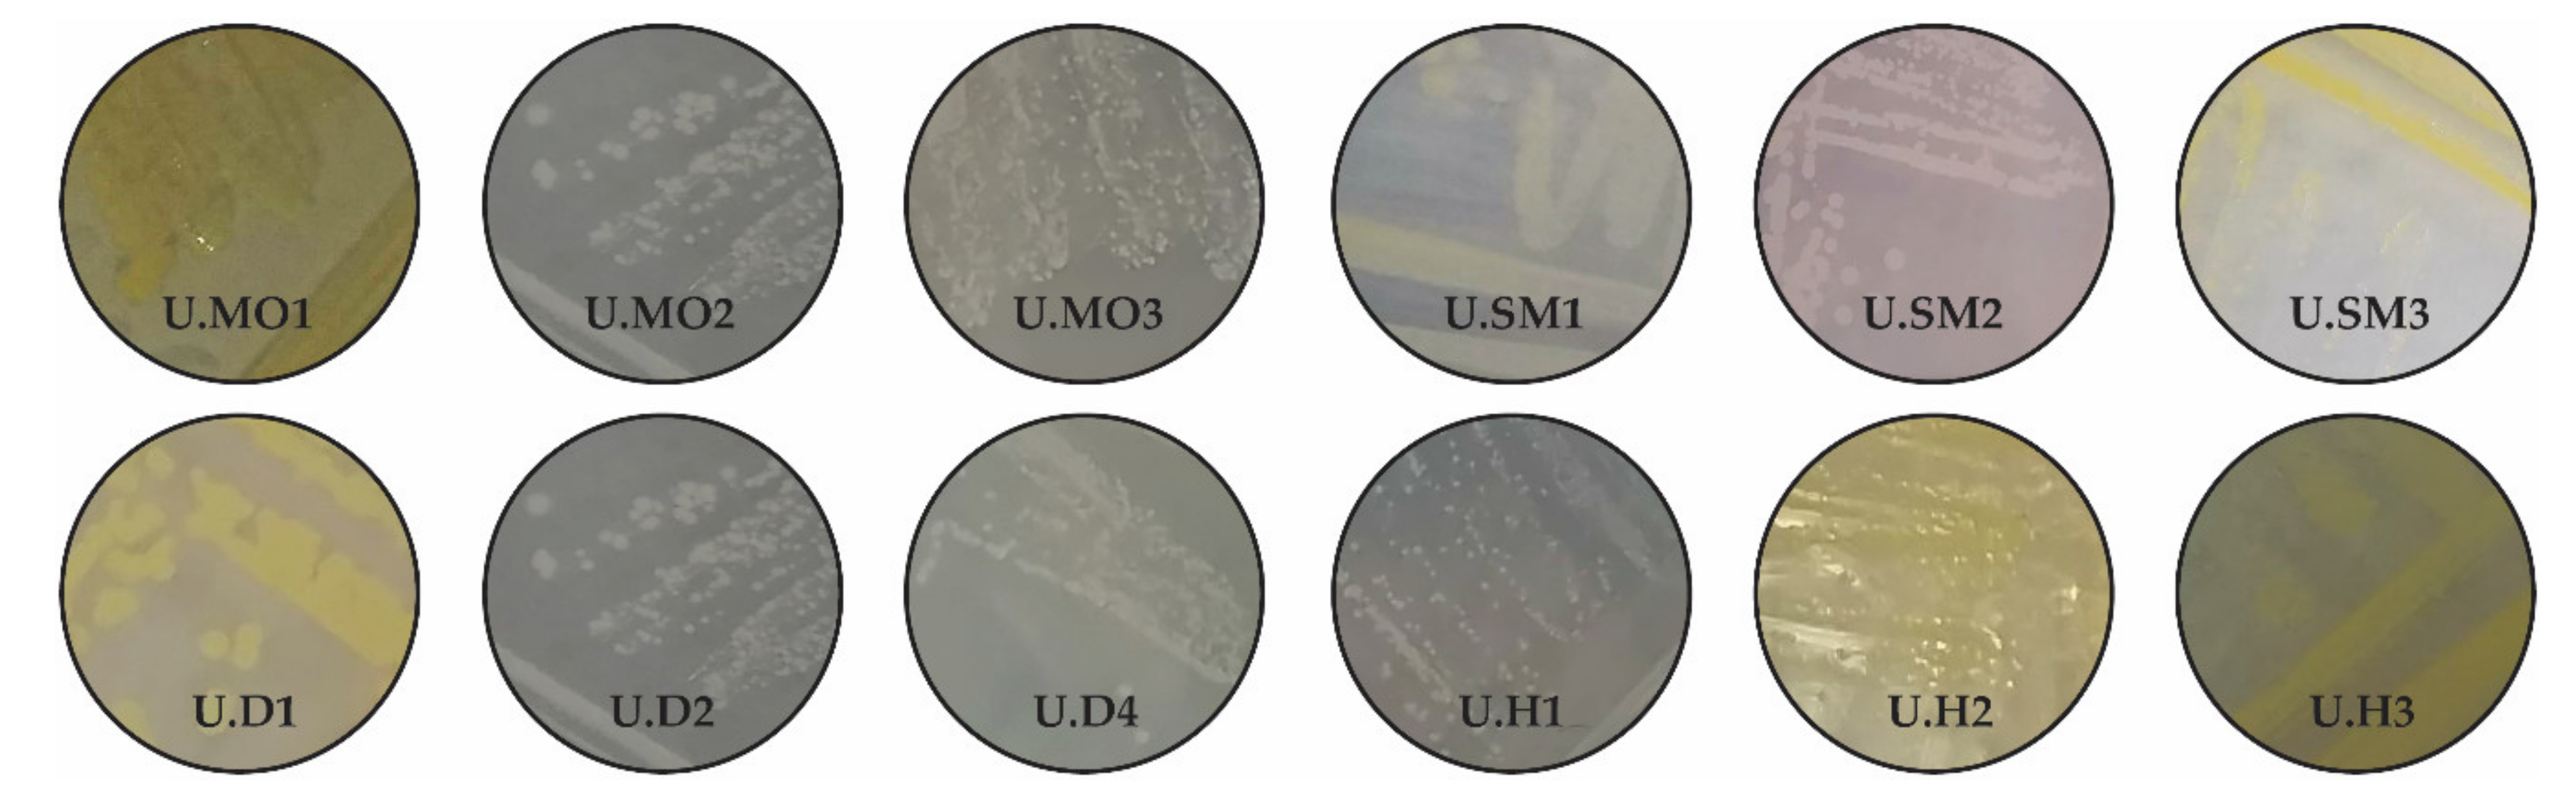
Biology 10 00409 g0a1 Biology 10 00409 g0a1

Bacterial Endophytes of Spring Wheat Grains and the Potential to Acquire Fe, Cu, and Zn under Their Low Soil Bioavailability
Abstract
Simple Summary
Abstract
1. Introduction
2. Materials and Methods
2.1. Plant Material and Soil Characteristics
2.2. Isolation of Bacterial Endophytes
2.3. Identification of Endophytic Bacterial Strains
2.4. Production of the IRCs
2.5. Estimation of the Yield and Content of Zinc, Iron, and Copper in the Grains
2.6. Statistical Analysis
3. Results
3.1. Identification of Isolated Endophytes
3.2. Synthesis of the IRCs
3.3. Grain Yields, Structure of the Harvest, and Concentrations of the Microelements
4. Discussion
5. Conclusions
Author Contributions
Funding
Institutional Review Board Statement
Informed Consent Statement
Data Availability Statement
Acknowledgments
Conflicts of Interest
Appendix A
| Culture Collection ID | Mean Concentration of DNA (µg·mL−1) ± SD | Mean A 260:280 Ratio ± SD | Mean A 260:230 Ratio ± SD |
|---|---|---|---|
| U.MO1 | 1202.02 ± 2.95 | 2.07 ± 0.00 | 1.97 ± 0.00 |
| U.MO2 | 1278.19 ± 6.61 | 1.99 ± 0.00 | 1.75 ± 0.00 |
| U.MO3 | 1010.06 ± 1.86 | 2.05 ± 0.00 | 1.87 ± 0.00 |
| U.SM1 | 914.39 ± 1.55 | 2.06 ± 0.00 | 1.67 ± 0.00 |
| U.SM2 | 708.86 ± 0.20 | 1.93 ± 0.00 | 1.04 ± 0.00 |
| U.SM3 | 272.88 ± 0.28 | 1.92 ± 0.00 | 1.35 ± 0.00 |
| U.D1 | 508.06 ± 0.34 | 2.01 ± 0.00 | 1.94 ± 0.00 |
| U.D2 | 542.37 ± 0.74 | 1.94 ± 0.01 | 0.94 ± 0.00 |
| U.D4 | 389.67 ± 1.23 | 1.99 ± 0.00 | 1.31 ± 0.01 |
| U.H1 | 96.75 ± 0.76 | 1.78 ± 0.00 | 1.08 ± 0.01 |
| U.H2 | 277.72 ± 0.46 | 1.97 ± 0.00 | 1.62 ± 0.00 |
| U.H3 | 357.57 ± 0.71 | 1.88 ± 0.00 | 1.64 ± 0.00 |
| Primer (5′–3′) | References | |
|---|---|---|
| 27F | AGAGTTTGATCATGGCTCAG | [168] |
| 1942R | TACCTTGTTACGACTT | [169] |
References
- Rojas, E.C.; Sapkota, R.; Jensen, B.; Jørgensen, H.J.L.; Henriksson, T.; Jørgensen, L.N.; Nicolaisen, M.; Collinge, D.B. Fusarium head blight modifies fungal endophytic communities during infection of wheat spikes. Microb. Ecol. 2020, 79, 397–408. [Google Scholar] [CrossRef]
- Curtin, D.; Martin, R.J.; Scott, C.L. Wheat (Triticum aestivum) response to micronutrients (Mn, Cu, Zn, B) in Canterbury, New Zealand. N. Z. J. Crop Hortic. Sci. 2008, 36, 169–181. [Google Scholar] [CrossRef]
- Bhatt, R.; Hossain, A.; Sharma, P. Zinc biofortification as an innovative technology to alleviate the zinc deficiency in human health. Open Agric. 2020, 5, 176–187. [Google Scholar] [CrossRef]
- Cu, S.T.; Guild, G.; Nicolson, A.; Velu, G.; Singh, R.; Stangoulis, J. Genetic dissection of Zinc, Iron, Copper, Manganese and Phosphorus in wheat (Triticum aestivum L.) grain and rachis at two developmental stages. Plant Sci. 2020, 291, 110338. [Google Scholar] [CrossRef] [PubMed]
- Gupta, P.K.; Balyan, H.S.; Sharma, S.; Kumar, R. Biofortification and bioavailability of Zn, Fe and Se in wheat: Present status and future prospects. Theor. Appl. Genet. 2021, 134, 1–35. [Google Scholar] [CrossRef] [PubMed]
- Monasterio, I.; Graham, R.D. Breeding for Trace Minerals in Wheat. Food Nutr. Bull. 2000, 21, 392–396. [Google Scholar] [CrossRef]
- Cakmak, I.; Kalayci, M.; Kaya, Y.; Torun, A.A.; Aydin, N.; Wang, Y.; Arisoy, Z.; Erdem, H.; Yazici, A.; Gokmen, O.; et al. Biofortification and Localization of Zinc in Wheat Grain. J. Agric. Food Chem. 2010, 58, 9092–9102. [Google Scholar] [CrossRef]
- Cakmak, I.; Torun, A.; Millet, E.; Feldman, M.; Fahima, T.; Korol, A.; Nevo, E.; Braun, H.J.; Özkan, H. Triticum dicoccoides: An important genetic resource for increasing Zinc and Iron concentration in modern cultivated wheat. Soil Sci. Plant Nutr. 2004, 50, 1047–1054. [Google Scholar] [CrossRef]
- White, P.J.; Broadley, M.R. Biofortification of crops with seven mineral elements often lacking in human diets—Iron, Zinc, Copper, Calcium, Magnesium, Selenium and Iodine. New Phytol. 2009, 182, 49–84. [Google Scholar] [CrossRef]
- Niyigaba, E.; Twizerimana, A.; Mugenzi, I.; Ngnadong, W.A.; Ye, Y.P.; Wu, B.M.; Hai, J.B. Winter wheat grain quality, Zinc and Iron concentration affected by a combined foliar spray of Zinc and Iron fertilizers. Agronomy 2019, 9, 250. [Google Scholar] [CrossRef]
- Gupta, O.P.; Pandey, V.; Saini, R.; Narwal, S.; Malik, V.K.; Khandale, T.; Ram, S.; Singh, G.P. Identifying transcripts associated with efficient transport and accumulation of Fe and Zn in hexaploid wheat (T. aestivum L.). J. Biotechnol. 2020, 316, 46–55. [Google Scholar] [CrossRef]
- Arzani, A. Emmer (Triticum turgidum ssp. dicoccum) flour and bread. In Flour and Breads and Their Fortification in Health and Disease Prevention; Academic Press: Cambridge, MA, USA, 2019; pp. 89–98. [Google Scholar] [CrossRef]
- Serpen, A.; Gökmen, V.; Karagöz, A.; Köksel, H. Phytochemical quantification and total antioxidant capacities of emmer (Triticum dicoccon schrank) and einkorn (Triticum monococcum L.) wheat landraces. J. Agric. Food Chem. 2008, 56, 7285–7292. [Google Scholar] [CrossRef]
- Christopher, A.; Sarkar, D.; Zwinger, S.; Shetty, K. Ethnic food perspective of north Dakota common emmer wheat and relevance for health benefits targeting type 2 diabetes. J. Ethnic Foods 2018, 5, 66–74. [Google Scholar] [CrossRef]
- Tekin, M.; Cengiz, M.F.; Abbasov, M.; Aksoy, A.; Canci, H.; Akar, T. Comparison of some mineral nutrients and vitamins in advanced hulled wheat lines. Cereal Chem. 2018, 95, 436–444. [Google Scholar] [CrossRef]
- Suchowilska, E.; Wiwart, M.; Kandler, W.; Krska, R. A comparison of macro- and microelement concentrations in the whole grain of four Triticum species. Plant Soil Environ. 2012, 58, 141–147. [Google Scholar] [CrossRef]
- Sheng, H.; Jiang, Y.; Rahmati, M.; Chia, J.-C.; Dokuchayeva, T.; Kavulych, Y.; Zavodna, T.-O.; Mendoza, P.N.; Huang, R.; Smieshka, L.M.; et al. YSL3-mediated Copper distribution is required for fertility, seed size and protein accumulation in Brachypodium. Plant Physiol. 2021, kiab054. [Google Scholar] [CrossRef]
- Alloway, B.J. Micronutrients and crop production: An Introduction. In Micronutrient Deficiencies in Global Crop Production; Alloway, B.J., Ed.; Springer: Dordrecht, The Netherlands, 2008; pp. 1–39. [Google Scholar] [CrossRef]
- Alloway, B.J. Zinc in Soils and Crop Nutrition; International Zinc Association: Belgium, Brussels, 2004; p. 30. [Google Scholar]
- Broadley, M.; Brown, P.; Cakmak, I.; Rengel, Z.; Zhao, F. Function of nutrients. In Marschner’s Mineral Nutrition of Higher Plants; Academic Press: Cambridge, MA, USA, 2021; pp. 191–248. [Google Scholar] [CrossRef]
- Ramzan, Y.; Hafeez, M.B.; Khan, S.; Nadeem, M.; Saleem-ur-Rahman; Batool, S.; Ahmad, J. Biofortification with Zinc and Iron improves the grain quality and yield of wheat crop. Int. J. Plant Prod. 2020, 14, 501–510. [Google Scholar] [CrossRef]
- Das, S.; Chaki, A.K.; Hossain, A. Breeding and agronomic approaches for the biofortification of zinc in wheat (Triticum aestivum L.) to combat zinc deficiency in millions of a population: A Bangladesh perspective. Acta Agrobot. 2019, 72. [Google Scholar] [CrossRef]
- Kumar, D.S.S.; Hyde, K.D. Biodiversity and tissue-recurrence of endophytic fungi in Tripterygium wilfordii. Fungal Divers. 2004, 17, 69–90. [Google Scholar]
- Pimentel, M.R.; Molina, G.; Dionísio, A.P.; Maróstica Junior, M.R.; Pastore, G.M. The use of endophytes to obtain bioactive compounds and their application in biotransformation process. Biotechnol. Res. Int. 2011, 1–11. [Google Scholar] [CrossRef]
- Abaid-Ullah, M.; Hassan, M.N.; Jamil, M.; Brader, G.; Shah, M.K.N.; Sessitsch, A.; Hafeez, F.Y. Plant growth promoting rhizobacteria: An alternate way to improve yield and quality of wheat (Triticum aestivum). Int. J. Agric. Biol. 2015, 17, 51–60. [Google Scholar]
- Rana, A.; Kabi, S.R.; Verma, S.; Adak, A.; Pal, M.; Shivay, Y.S.; Prasanna, R.; Nain, L. Prospecting plant growth promoting bacteria and cyanobacteria as options for enrichment of macro- and micronutrients in grains in rice–wheat cropping sequence. Cogent Food Agric. 2015, 1, 1037379. [Google Scholar] [CrossRef]
- Prasanna, R.; Bidyarani, N.; Babu, S.; Hossain, F.; Shivay, Y.S.; Nain, L. Cyanobacterial inoculation elicits plant defense response and enhanced Zn mobilization in maize hybrids. Cogent Food Agric. 2015, 1, 998507. [Google Scholar] [CrossRef]
- Mundt, J.O.; Hinkle, N.F. Bacteria within ovules and seeds. Appl. Environ. Microbiol. 1976, 32, 694–698. [Google Scholar] [CrossRef]
- Kremer, R.J. Identity and properties of bacteria inhabiting seeds of selected broadleaf weed species. Microb. Ecol. 1987, 14, 29–37. [Google Scholar] [CrossRef]
- Schardl, C.L.; Leuchtmann, A.; Spiering, M.J. Symbioses of grasses with seedborne fungal endophytes. Annu. Rev. Plant Biol. 2004, 55, 315–340. [Google Scholar] [CrossRef]
- Battu, L.; Reddy, M.M.; Goud, B.S.; Ulaganathan, K.; Kandasamy, U. Genome inside genome: NGS based identification and assembly of endophytic Sphingopyxis granuli and Pseudomonas aeruginosa genomes from rice genomic reads. Genomics 2017, 109, 141–146. [Google Scholar] [CrossRef]
- Oita, S.; Carey, J.; Kline, I.; Ibáñez, A.; Yang, N.; Hom, E.F.Y.; Carbone, I.; U’Ren, J.M.; Arnold, A.E. Methodological approaches frame insights into endophyte richness and community composition. Microb. Ecol. 2021. [Google Scholar] [CrossRef]
- Johnston-Monje, D.; Raizada, M.N. Plant and endophyte relationships. Compr. Biotech. 2011, 4, 713–727. [Google Scholar] [CrossRef]
- Kushwaha, P.; Kashyap, P.L.; Bhardwaj, A.K.; Kuppusamy, P.; Srivastava, A.K.; Tiwari, R.K. Bacterial endophyte mediated plant tolerance to salinity: Growth responses and mechanisms of action. World J. Microbiol. Biotech. 2020, 36, 26. [Google Scholar] [CrossRef]
- Zhang, P.; Zhu, Y.; Ma, D.; Xu, W.; Zhou, J.; Yan, H.; Yang, L.; Yin, J. Screening, identification, and optimization of fermentation conditions of an antagonistic endophyte to wheat head blight. Agronomy 2019, 9, 476. [Google Scholar] [CrossRef]
- Gouda, S.; Das, G.; Sen, S.K.; Shin, H.-S.; Patra, J.K. Endophytes: A treasure house of bioactive compounds of medicinal importance. Front. Microbiol. 2016, 7. [Google Scholar] [CrossRef]
- Singh, D.; Rajawat, M.V.S.; Kaushik, R.; Prasanna, R.; Saxena, A.K. Beneficial role of endophytes in biofortification of Zn in wheat genotypes varying in nutrient use efficiency grown in soils sufficient and deficient in Zn. Plant Soil 2017, 416, 107–116. [Google Scholar] [CrossRef]
- Jayakumar, A.; Krishna, A.; Nair, I.C.; Radhakrishnan, E.K. Drought-tolerant and plant growth-promoting endophytic Staphylococcus sp. having synergistic effect with silicate supplementation. Arch. Microbiol. 2020, 202, 1899–1906. [Google Scholar] [CrossRef]
- Matthijs, S.; Tehrani, K.A.; Laus, G.; Jackson, R.W.; Cooper, R.M.; Cornelis, P. Thioquinolobactin, a Pseudomonas siderophore with antifungal and anti-Pythium activity. Environ. Microbiol. 2007, 9, 425–434. [Google Scholar] [CrossRef]
- Ek-Ramos, M.J.; Gomez-Flores, R.; Orozco-Flores, A.A.; Rodríguez-Padilla, C.; González-Ochoa, G.; Tamez-Guerra, P. Bioactive products from plant-endophytic gram-positive bacteria. Front. Microbiol. 2019, 10, 463. [Google Scholar] [CrossRef]
- Reinhold-Hurek, B.; Hurek, T. Living inside plants: Bacterial endophytes. Curr. Opin. Plant. Biol. 2011, 14, 435–443. [Google Scholar] [CrossRef]
- Brader, G.; Compant, S.; Mitter, B.; Trognitz, F.; Sessitsch, A. Metabolic potential of endophytic bacteria. Curr. Opin. Biotechnol. 2014, 27, 30–37. [Google Scholar] [CrossRef]
- Santoyo, G.; Moreno-Hagelsieb, G.; del Carmen Orozco-Mosqueda, M.; Glick, B.R. Plant growth-promoting bacterial endophytes. Microbiol. Res. 2016, 183, 92–99. [Google Scholar] [CrossRef]
- Shahzad, R.; Waqas, M.; Khan, A.L.; Asaf, S.; Khan, M.A.; Kang, S.-M.; Yun, B.-W.; Lee, I.-J. Seed-borne endophytic Bacillus amyloliquefaciens RWL-1 produces gibberellins and regulates endogenous phytohormones of Oryza sativa. Plant Physiol. Biochem. 2016, 106, 236–243. [Google Scholar] [CrossRef]
- Chen, C.; Bauske, E.M.; Musson, G.; Rodriguezkabana, R.; Kloepper, J.W. Biological control of Fusarium wilt on cotton by use of endophytic bacteria. Biol. Control 1995, 5, 83–91. [Google Scholar] [CrossRef]
- Hallmann, J.; Berg, G. Spectrum and population dynamics of bacterial root endophytes. Microb. Root Endophyt. 2006, 9, 15–31. [Google Scholar] [CrossRef]
- Rodriguez, R.; Redman, R. More than 400 million years of evolution and some plants still can’t make it on their own: Plant stress tolerance via fungal symbiosis. J. Exp. Bot. 2008, 59, 1109–1114. [Google Scholar] [CrossRef]
- Žiarovská, J.; Medo, J.; Kyseľ, M.; Zamiešková, L.; Kačániová, M. Endophytic bacterial microbiome diversity in early developmental stage plant tissues of wheat varieties. Plants 2020, 9, 266. [Google Scholar] [CrossRef]
- Ridout, M.E.; Schroeder, K.L.; Hunter, S.S.; Styer, J.; Newcombe, G. Priority effects of wheat seed endophytes on a rhizosphere symbiosis. Symbiosis 2019, 78, 19–31. [Google Scholar] [CrossRef]
- Chen, C.; Xin, K.; Liu, H.; Cheng, J.; Shen, X.; Wang, Y.; Zhang, L. Pantoea alhagi, a novel endophytic bacterium with ability to improve growth and drought tolerance in wheat. Sci. Rep. 2017, 7, 41564. [Google Scholar] [CrossRef]
- Rana, K.L.; Kour, D.; Kaur, T.; Sheikh, I.; Yadav, A.N.; Kumar, V.; Suman, A.; Dhaliwal, H.S. Endophytic microbes from diverse wheat genotypes and their potential biotechnological applications in plant growth promotion and nutrient uptake. Proc. Natl. Acad. Sci. India Sect. B Biol. Sci. 2020, 90, 969–979. [Google Scholar] [CrossRef]
- Tyc, O.; Putra, R.; Gols, R.; Harvey, J.A.; Garbeva, P. The ecological role of bacterial seed endophytes associated with wild cabbage in the United Kingdom. Microbiol. Open 2020, 9. [Google Scholar] [CrossRef] [PubMed]
- Singh, D.; Geat, N.; Rajawat, M.V.S.; Prasanna, R.; Kar, A.; Singh, A.M.; Saxena, A.K. Prospecting endophytes from different Fe or Zn accumulating wheat genotypes for their influence as inoculants on plant growth, yield, and micronutrient content. Ann. Microbiol. 2018, 68, 815–833. [Google Scholar] [CrossRef]
- Hussain, A.; Arshad, M.; Zahir, Z.A.; Asghar, M. Prospects of Zinc solubilizing bacteria for enhancing growth of maize. Pak. J. Agric. Sci. 2015, 52, 915–922. [Google Scholar]
- Verma, P.; Yadav, A.N.; Khannam, K.S.; Panjiar, N.; Kumar, S.; Saxena, A.K.; Suman, A. Assessment of genetic diversity and plant growth promoting attributes of psychrotolerant bacteria allied with wheat (Triticum aestivum) from the northern hills zone of India. Ann. Microbiol. 2015, 65, 1885–1899. [Google Scholar] [CrossRef]
- Fasim, F.; Ahmed, N.; Parsons, R.; Gadd, G.M. Solubilization of Zinc salts by a bacterium isolated from the air environment of a Tannery. FEMS Microbiol. 2002, 213, 1–6. [Google Scholar] [CrossRef]
- Kamran, S.; Shahid, I.; Baig, D.N.; Rizwan, M.; Malik, K.A.; Mehnaz, S. Contribution of zinc solubilizing bacteria in growth promotion and zinc content of wheat. Front. Microbiol. 2017, 8, 2593. [Google Scholar] [CrossRef]
- Singh, D.; Prasanna, R. Potential of microbes in the biofortification of Zn and Fe in dietary food grains. A review. Agron. Sustain. Dev. 2020, 40. [Google Scholar] [CrossRef]
- Rehman, A.; Farooq, M.; Naveed, M.; Nawaz, A.; Shahzad, B. Seed priming of Zn with endophytic bacteria improves the productivity and grain biofortification of bread wheat. Eur. J. Agronomy 2018, 94, 98–107. [Google Scholar] [CrossRef]
- White, P.; Pongrac, P.; Sneddon, C.; Thompson, J.; Wright, G. Limits to the biofortification of leafy brassicas with Zinc. Agriculture 2018, 8, 32. [Google Scholar] [CrossRef]
- Ramesh, A.; Sharma, S.K.; Sharma, M.P.; Yadav, N.; Joshi, O.P. Inoculation of Zinc solubilizing Bacillus aryabhattai strains for improved growth, mobilization and biofortification of Zinc in soybean and wheat cultivated in Vertisols of central India. Appl. Soil Ecol. 2014, 73, 87–96. [Google Scholar] [CrossRef]
- Dos Santos, M.L.; Berlitz, D.L.; Wiest, S.L.F.; Schünemann, R.; Knaak, N.; Fiuza, L.M. Benefits associated with the interaction of endophytic bacteria and plants. Braz. Arch. Biol. Technol. 2018, 61. [Google Scholar] [CrossRef]
- Hardoim, P.R.; van Overbeek, L.S.; Berg, G.; Pirttilä, A.M.; Compant, S.; Campisano, A.; Döring, M.; Sessitsch, A. The hidden world within plants: Ecological and evolutionary considerations for defining functioning of microbial endophytes. Microbiol. Mol. Biol. Rev. 2015, 79, 293–320. [Google Scholar] [CrossRef]
- Truyens, S.; Weyens, N.; Cuypers, A.; Vangronsveld, J. Bacterial seed endophytes: Genera, vertical transmission and interaction with plants: Bacterial seed endophytes. Environ. Microbiol. Rep. 2015, 7, 40–50. [Google Scholar] [CrossRef]
- Compant, S.; Cambon, M.C.; Vacher, C.; Mitter, B.; Samad, A.; Sessitsch, A. The plant endosphere world—Bacterial life within plants. Environ. Microbiol. 2020, 23, 1812–1829. [Google Scholar] [CrossRef] [PubMed]
- Safin, R.I.; Karimova, L.Z.; Nizamov, R.M.; Valiev, A.R.; Validov, S.Z.; Faizrakhmanov, D.I. Features of seeds microbiome for spring wheat varieties from different regions of Eurasia. Adv. Engin. Res. 2018, 151, 766–770. [Google Scholar] [CrossRef]
- Comby, M.; Lacoste, S.; Baillieul, F.; Profizi, C.; Dupont, J. Spatial and temporal variation of cultivable communities of co-occurring endophytes and pathogens in wheat. Front. Microbiol. 2016, 7. [Google Scholar] [CrossRef] [PubMed]
- Kuźniar, A.; Włodarczyk, K.; Grządziel, J.; Woźniak, M.; Furtak, K.; Gałązka, A.; Dziadczyk, E.; Skórzyńska-Polit, E.; Wolińska, A. New insight into the composition of wheat seed microbiota. Int. J. Mol. Sci. 2020, 21, 4634. [Google Scholar] [CrossRef]
- Özkurt, E.; Hassani, M.A.; Sesiz, U.; Künzel, S.; Dagan, T.; Özkan, H.; Stukenbrock, E.H. Seed-derived microbial colonization of wild emmer and domesticated bread wheat (Triticum dicoccoides and T. aestivum) seedlings shows pronounced differences in overall diversity and composition. mBio 2020, 11, e02637-20. [Google Scholar] [CrossRef]
- Solanki, M.K.; Abdelfattah, A.; Britzi, M.; Zakin, V.; Wisniewski, M.; Droby, S.; Sionov, E. Shifts in the composition of the microbiota of stored wheat grains in response to fumigation. Front. Microbiol. 2019, 10, 1098. [Google Scholar] [CrossRef]
- Tao, A.; Pang, F.; Huang, S.; Yu, G.; Li, B.; Wang, T. Characterisation of endophytic Bacillus thuringiensis strains isolated from wheat plants as biocontrol agents against wheat flag smut. Biocontrol Sci. Technol. 2014, 24, 901–924. [Google Scholar] [CrossRef]
- Pan, D.; Mionetto, A.; Tiscornia, S.; Bettucci, L. Endophytic bacteria from wheat grain as biocontrol agents of Fusarium graminearum and deoxynivalenol production in wheat. Mycotoxin Res. 2015, 31, 137–143. [Google Scholar] [CrossRef]
- Cherif-Silini, H.; Silini, A.; Yahiaoui, B.; Ouzari, I.; Boudabous, A. phylogenetic and plant-growth-promoting characteristics of bacillus isolated from the wheat rhizosphere. Ann. Microbiol. 2016, 66, 1087–1097. [Google Scholar] [CrossRef]
- White, J.F.; Kingsley, K.L.; Zhang, Q.; Verma, R.; Obi, N.; Dvinskikh, S.; Elmore, M.T.; Verma, S.K.; Gond, S.K.; Kowalski, K.P. Review: Endophytic microbes and their potential applications in crop management. Pest. Manag. Sci. 2019, 75, 2558–2565. [Google Scholar] [CrossRef]
- Makar, O.O.; Patsula, O.I.; Kavulych, Y.Z.; Batrashkina, T.I.; Bunio, L.V.; Kozlovskyy, V.I.; Vatamaniuk, O.; Terek, O.I.; Romanyuk, N.D. Excized leaf water status as a measure of drought resistance of Ukrainian spring wheat. Biol. Stud. 2019, 13, 41–54. [Google Scholar] [CrossRef]
- Sambrook, J.; Fritsch, E.F.; Maniatis, T. Molecular Cloning: A Laboratory Manual; Cold Spring Harbor Laboratory: Cold Spring Harbor, NY, USA, 1989. [Google Scholar]
- Gordon, S.A.; Weber, R.P. Colorimetric estimation of indoleacetic acid. Plant Physiol. 1951, 26, 192–195. [Google Scholar] [CrossRef]
- Šimoliūnas, E.; Šimoliūnienė, M.; Kaliniene, L.; Zajančkauskaitė, A.; Skapas, M.; Meškys, R.; Kaupinis, A.; Valius, M.; Truncaitė, L. Pantoea bacteriophage VB_PagS_Vid5: A low-temperature siphovirus that harbors a cluster of genes involved in the biosynthesis of archaeosine. Viruses 2018, 10, 583. [Google Scholar] [CrossRef]
- Zhang, L.; Hu, Q.; Liu, B.; Li, F.; Jiang, J.-D. Characterization of a linuron-specific amidohydrolase from the newly isolated bacterium Sphingobium sp. Strain SMB. J. Agric. Food Chem. 2020, 68, 4335–4345. [Google Scholar] [CrossRef]
- Balasundararajan, V.; Dananjeyan, B. occurrence of diversified N-acyl homoserine lactone mediated biofilm-forming bacteria in rice rhizoplane. J. Basic Microbiol. 2019, 59, 1031–1039. [Google Scholar] [CrossRef]
- Chaudhry, V.; Patil, P.B. Genomic investigation reveals evolution and lifestyle adaptation of endophytic Staphylococcus epidermidis. Sci. Rep. 2016, 6, 19263. [Google Scholar] [CrossRef]
- Madhaiyan, M.; Alex, T.H.H.; Ngoh, S.T.; Prithiviraj, B.; Ji, L. Leaf-residing Methylobacterium species fix nitrogen and promote biomass and seed production in Jatropha curcas. Biotechnol. Biofuels 2015, 8, 222. [Google Scholar] [CrossRef]
- Pham, T.M.; Wiese, J.; Wenzel-Storjohann, A.; Imhoff, J.F. Diversity and antimicrobial potential of bacterial isolates associated with the soft coral Alcyonium digitatum from the baltic sea. Antonie van Leeuwenhoek 2016, 109, 105–119. [Google Scholar] [CrossRef]
- Kasahara, H. Current aspects of auxin biosynthesis in plants. Biosci. Biotechnol. Biochem. 2016, 80, 34–42. [Google Scholar] [CrossRef]
- Narjesi, V.; Mardi, M.; Hervan, E.M.; Azadi, A.; Naghavi, M.R.; Ebrahimi, M.; Zali, A.A. Analysis of Quantitative Trait Loci (QTL) for grain yield and agronomic traits in wheat (Triticum aestivum L.) under normal and salt-stress conditions. Plant Mol. Biol. Rep. 2015, 33, 2030–2040. [Google Scholar] [CrossRef]
- Zhang, H.; Chen, J.; Li, R.; Deng, Z.; Zhang, K.; Liu, B.; Tian, J. Conditional QTL Mapping of three yield components in common wheat (Triticum aestivum L.). Crop J. 2016, 4, 220–228. [Google Scholar] [CrossRef]
- Philipp, N.; Weichert, H.; Bohra, U.; Weschke, W.; Schulthess, A.W.; Weber, H. Grain number and grain yield distribution along the spike remain stable despite breeding for high yield in winter wheat. PLoS ONE 2018, 13, e0205452. [Google Scholar] [CrossRef]
- Kobayashi, T.; Nozoye, T.; Nishizawa, N.K. Iron transport and its regulation in plants. Free Radic. Biol. Med. 2019, 133, 11–20. [Google Scholar] [CrossRef]
- Hänsch, R.; Mendel, R.R. Physiological functions of mineral micronutrients (Cu, Zn, Mn, Fe, Ni, Mo, B, Cl). Curr. Opin. Plant Biol. 2009, 12, 259–266. [Google Scholar] [CrossRef] [PubMed]
- Epstein, E.; Bloom, A.J. Mineral Nutrition of Plants: Principles and Perspectives, 2nd ed.; Sinauer Associates, Incorporated: Sunderland, MA, USA, 2005. [Google Scholar]
- Tavallali, V.; Rahemi, M.; Eshghi, S.; Kholdebarin, B.; Ramezanian, A. Zinc alleviates salt stress and increases antioxidant enzyme activity in the leaves of pistachio (Pistacia vera L. ‘Badami’) seedlings. Turk. J. Agric. For. 2010, 34, 349–359. [Google Scholar] [CrossRef]
- Rout, G.R.; Sahoo, S. Role of iron in plant growth and metabolism. Rev. Agric. Sci. 2015, 3, 1–24. [Google Scholar] [CrossRef]
- Tognetti, V.B.; Zurbriggen, M.D.; Morandi, E.N.; Fillat, M.F.; Valle, E.M.; Hajirezaei, M.-R.; Carrillo, N. Enhanced plant tolerance to iron starvation by functional substitution of chloroplast ferredoxin with a bacterial flavodoxin. Proc. Natl. Acad. Sci. USA 2007, 104, 11495–11500. [Google Scholar] [CrossRef]
- Zhang, X.; Zhang, D.; Sun, W.; Wang, T. The adaptive mechanism of plants to Iron deficiency via Iron uptake, transport, and homeostasis. Int. J. Mol. Sci. 2019, 20, 2424. [Google Scholar] [CrossRef]
- Kabir, A.H.; Paltridge, N.G.; Roessner, U.; Stangoulis, J.C.R. Mechanisms associated with Fe-deficiency tolerance and signaling in shoots of Pisum sativum. Physiol. Plantarum 2013, 147, 381–395. [Google Scholar] [CrossRef] [PubMed]
- Kabir, A.H.; Debnath, T.; Das, U.; Prity, S.A.; Haque, A.; Rahman, M.M.; Parvez, M.S. Arbuscular mycorrhizal fungi alleviate Fe-deficiency symptoms in sunflower by increasing Iron uptake and its availability along with antioxidant defense. Plant Physiol. Biochem. 2020, 150, 254–262. [Google Scholar] [CrossRef] [PubMed]
- Burkhead, J.L.; Gogolin Reynolds, K.A.; Abdel-Ghany, S.E.; Cohu, C.M.; Pilon, M. Copper homeostasis. New Phytol. 2009, 182, 799–816. [Google Scholar] [CrossRef]
- Ishka, M.R.; Vatamaniuk, O.K. Copper deficiency alters shoot architecture and reduces fertility of both gynoecium and androecium in Arabidopsis thaliana. Plant Direct. 2020, 4. [Google Scholar] [CrossRef]
- Chatrath, R.; Gupta, V.; Parkash, O.; Singh, G.P. Evaluation of biofortified spring wheat genotypes for yield and micronutrients. J. Appl. Natl. Sci. 2018, 10, 210–215. [Google Scholar] [CrossRef]
- Pandey, A.; Khan, M.K.; Hakki, E.E.; Thomas, G.; Hamurcu, M.; Gezgin, S.; Gizlenci, O.; Akkaya, M.S. Assessment of genetic variability for grain nutrients from diverse regions: Potential for wheat improvement. SpringerPlus 2016, 5, 1912. [Google Scholar] [CrossRef]
- Zhao, F.J.; Su, Y.H.; Dunham, S.J.; Rakszegi, M.; Bedo, Z.; McGrath, S.P.; Shewry, P.R. Variation in mineral micronutrient concentrations in grain of wheat lines of diverse origin. J. Cereal. Sci. 2009, 49, 290–295. [Google Scholar] [CrossRef]
- Mondini, L.; Grausgruber, H.; Pagnotta, M.A. Evaluation of European emmer wheat germplasm for agro-morphological, grain quality traits and molecular traits. Genet. Resour. Crop Evol. 2014, 61, 69–87. [Google Scholar] [CrossRef]
- Hocking, P.J. Dry-matter production, mineral nutrient concentrations, and nutrient distribution and redistribution in irrigated spring wheat. J. Plant Nutr. 1994, 17, 1289–1308. [Google Scholar] [CrossRef]
- Miller, R.O.; Jacobsen, J.S.; Skogley, E.O. Aerial accumulation and partitioning of nutrients by hard red spring wheat. Commun. Soil Sci. Plant Anal. 1994, 25, 1891–1911. [Google Scholar] [CrossRef]
- Garnett, T.P.; Graham, R.D. Distribution and remobilization of iron and copper in wheat. Ann. Bot. 2005, 95, 817–826. [Google Scholar] [CrossRef]
- Pahlavan-Rad, M.R.; Pessarakli, M. Response of wheat plants to zinc, iron, and manganese applications and uptake and concentration of zinc, iron, and manganese in wheat grains. Commun. Soil Sci. Plant Anal. 2009, 40, 1322–1332. [Google Scholar] [CrossRef]
- Printz, B.; Lutts, S.; Hausman, J.-F.; Sergeant, K. Copper trafficking in plants and its implication on cell wall dynamics. Front. Plant Sci. 2016, 7. [Google Scholar] [CrossRef]
- Yaseen, M.; Abbas, T.; Aziz, M.Z.; Wakeel, A.; Yasmeen, H.; Ahmed, W.; Ullah, A.; Naveed, M. Microbial assisted foliar feeding of micronutrients enhance growth, yield and biofortification of wheat. Int. J. Agric. Biol. 2018, 353–360. [Google Scholar] [CrossRef]
- Muhae-Ud-Din, G.; Ali, M.A.; Naveed, M.; Naveed, K.; Abbas, A.; Anwar, J.; Tanveer, M.H. Consortium application of endophytic bacteria and fungi improves grain yield and physiological attributes in advanced lines of bread wheat. Turk. JAF Sci. Tech. 2018, 6, 136. [Google Scholar] [CrossRef]
- Woźniak, M.; Gałązka, A.; Tyśkiewicz, R.; Jaroszuk-Ściseł, J. Endophytic bacteria potentially promote plant growth by synthesizing different metabolites and their phenotypic/physiological profiles in the Biolog GEN III MicroPlateTM Test. Int. J. Mol. Sci. 2019, 20, 5283. [Google Scholar] [CrossRef]
- Patten, C.; Glick, B.R. Bacterial biosynthesis of indole-3-acetic acid. Can. J. Microbiol. 1996, 42, 207–220. [Google Scholar] [CrossRef]
- Zahir, A.; Abbas, S.A.; Khalid, M.; Arshad, M. Structure dependent microbially derived plant hormones by improving growth of maize seedlings. Pak. J. Biol. Sci. 2000, 3, 289–291. [Google Scholar] [CrossRef]
- Passari, A.K.; Mishra, V.K.; Singh, G.; Singh, P.; Kumar, B.; Gupta, V.K.; Sarma, R.K.; Saikia, R.; Donovan, A.O.; Singh, B.P. Insights into the functionality of endophytic actinobacteria with a focus on their biosynthetic potential and secondary metabolites production. Sci. Rep. 2017, 7, 11809. [Google Scholar] [CrossRef]
- Hardoim, P.R. Biologically active compounds from bacterial endophytes. In Endophytes and Secondary Metabolites; Reference Series in Phytochemistry; Jha, S., Ed.; Springer: Cham, Switzerland, 2019. [Google Scholar] [CrossRef]
- Gross, H.; Loper, J.E. Genomics of secondary metabolite production by Pseudomonas spp. Nat. Prod. Rep. 2009, 26, 1408–1446. [Google Scholar] [CrossRef] [PubMed]
- Qi, Y.; Wang, S.; Shen, C.; Zhang, S.; Chen, Y.; Xu, Y.; Liu, Y.; Wu, Y.; Jiang, D. OsARF12, a Transcription activator on auxin response gene, regulates root elongation and affects iron accumulation in rice (Oryza sativa). New Phytol. 2012, 193, 109–120. [Google Scholar] [CrossRef] [PubMed]
- Xu, Y.; Zhang, S.; Guo, H.; Wang, S.; Xu, L.; Li, C.; Qian, Q.; Chen, F.; Geisler, M.; Qi, Y.; et al. OsABCB14 Functions in auxin transport and iron homeostasis in rice (Oryza sativa L.). Plant J. 2014, 79, 106–117. [Google Scholar] [CrossRef] [PubMed]
- Garnica, M.; Bacaicoa, E.; Mora, V.; San Francisco, S.; Baigorri, R.; Zamarreño, A.M.; Garcia-Mina, J.M. Shoot iron status and auxin are involved in iron deficiency-induced phytosiderophores release in wheat. BMC Plant Biol. 2018, 18, 105. [Google Scholar] [CrossRef]
- Kabir, A.H.; Khatun, M.A.; Hossain, M.M.; Haider, S.A.; Alam, M.F.; Paul, N.K. Regulation of phytosiderophore release and antioxidant defense in roots driven by shoot-based auxin signaling confers tolerance to excess iron in wheat. Front. Plant Sci. 2016, 7. [Google Scholar] [CrossRef]
- Begum, M.C.; Islam, M.; Sarkar, M.R.; Azad, M.A.S.; Huda, A.K.M.N.; Kabir, A.H. Auxin signaling is closely associated with Zn-efficiency in rice (Oryza sativa L.). J. Plant Interact. 2016, 11, 124–129. [Google Scholar] [CrossRef]
- Yamasaki, H.; Hayashi, M.; Fukazawa, M.; Kobayashi, Y.; Shikanai, T. SQUAMOSA promoter binding protein–like7 is a central regulator for Copper homeostasis in Arabidopsis. Plant Cell 2009, 21, 347–361. [Google Scholar] [CrossRef]
- Bernal, M.; Casero, D.; Singh, V.; Wilson, G.T.; Grande, A.; Yang, H.; Dodani, S.C.; Pellegrini, M.; Huijser, P.; Connolly, E.L.; et al. Transcriptome sequencing identifies SPL7 -regulated copper acquisition genes FRO4/FRO5 and the Copper dependence of iron homeostasis in Arabidopsis. Plant Cell 2012, 24, 738–761. [Google Scholar] [CrossRef]
- Yan, J.; Chia, J.-C.; Sheng, H.; Jung, H.; Zavodna, T.-O.; Zhang, L.; Huang, R.; Jiao, C.; Craft, E.J.; Fei, Z.; et al. Arabidopsis pollen fertility requires the transcription factors CITF1 and SPL7 that regulate copper delivery to anthers and jasmonic acid synthesis. Plant Cell 2017, 29, 3012–3029. [Google Scholar] [CrossRef]
- Wang, Y.; Hu, W.; Zhang, X.; Li, L.; Kang, G.; Feng, W.; Zhu, Y.; Wang, C.; Guo, T. Effects of cultivation patterns on winter wheat root growth parameters and grain yield. Field Crops Res. 2014, 156, 208–218. [Google Scholar] [CrossRef]
- Naveed, M.; Mitter, B.; Yousaf, S.; Pastar, M.; Afzal, M.; Sessitsch, A. The endophyte Enterobacter sp. FD17: A maize growth enhancer selected based on rigorous testing of plant beneficial traits and colonization characteristics. Biol. Fertil. Soils 2014, 50, 249–262. [Google Scholar] [CrossRef]
- Naveed, M.; Hussain, M.B.; Zahir, Z.A.; Mitter, B.; Sessitsch, A. Drought stress amelioration in wheat through inoculation with Burkholderia phytofirmans strain PsJN. Plant Growth Regul. 2014, 73, 121–131. [Google Scholar] [CrossRef]
- Haidar, B.; Ferdous, M.; Fatema, B.; Ferdous, A.S.; Islam, M.R.; Khan, H. Population diversity of bacterial endophytes from jute (Corchorus olitorius) and evaluation of their potential role as bioinoculants. Microbiol. Res. 2018, 208, 43–53. [Google Scholar] [CrossRef]
- Sofla, R.K.B.; Alikhani, H.; Etesami, H. Effect of Staphylococcus sp. bacteria isolated from salicornia plant on wheat growth. J. Water Soil Conserv. 2020, 26, 179–196. [Google Scholar] [CrossRef]
- Doolotkeldieva, T.D. Microbiological control of flour-manufacture: Dissemination of mycotoxins producing fungi in cereal products. Microbiol. Insights 2010, 3, MBI.S3822. [Google Scholar] [CrossRef]
- Bacon, C.W.; Hinton, D.M. Potential for control of seedling blight of wheat caused by Fusarium graminearum and related species using the bacterial endophyte Bacillus mojavensis. Biocontrol Sci. Technol. 2007, 17, 81–94. [Google Scholar] [CrossRef]
- Ntushelo, K.; Ledwaba, L.K.; Rauwane, M.E.; Adebo, O.A.; Njobeh, P.B. The mode of action of bacillus species against Fusarium graminearum, tools for investigation, and future prospects. Toxins 2019, 11, 606. [Google Scholar] [CrossRef] [PubMed]
- Khan, N.; Martínez-Hidalgo, P.; Ice, T.A.; Maymon, M.; Humm, E.A.; Nejat, N.; Sanders, E.R.; Kaplan, D.; Hirsch, A.M. Antifungal activity of Bacillus species against Fusarium and analysis of the potential mechanisms used in biocontrol. Front. Microbiol. 2018, 9, 2363. [Google Scholar] [CrossRef]
- Baffoni, L.; Gaggia, F.; Dalanaj, N.; Prodi, A.; Nipoti, P.; Pisi, A.; Biavati, B.; Di Gioia, D. Microbial inoculants for the biocontrol of Fusarium spp. in durum wheat. BMC Microbiol. 2015, 15, 242. [Google Scholar] [CrossRef] [PubMed]
- Comby, M.; Gacoin, M.; Robineau, M.; Rabenoelina, F.; Ptas, S.; Dupont, J.; Profizi, C.; Baillieul, F. Screening of wheat endophytes as biological control agents against fusarium head blight using two different in vitro tests. Microbiol. Res. 2017, 202, 11–20. [Google Scholar] [CrossRef]
- Sabaté, D.C.; Brandan, C.P.; Petroselli, G.; Erra-Balsells, R.; Audisio, M.C. Biocontrol of Sclerotinia sclerotiorum (Lib.) de bary on common bean by native lipopeptide-producer Bacillus strains. Microbiol. Res. 2018, 211, 21–30. [Google Scholar] [CrossRef]
- Duba, A.; Goriewa-Duba, K.; Wachowska, U. trichothecene genotypes analysis of fusarium isolates from di-, tetra- and hexaploid wheat. Agronomy 2019, 9, 698. [Google Scholar] [CrossRef]
- Ofek-Lalzar, M.; Gur, Y.; Ben-Moshe, S.; Sharon, O.; Kosman, E.; Mochli, E.; Sharon, A. Diversity of fungal endophytes in recent and ancient wheat ancestors Triticum dicoccoides and Aegilops sharonensis. FEMS Microbiol. Ecol. 2016, 92, fiw152. [Google Scholar] [CrossRef]
- Sun, X.; Kosman, E.; Sharon, A. Stem endophytic mycobiota in wild and domesticated wheat: Structural differences and hidden resources for wheat improvement. J. Fungi. 2020, 6, 180. [Google Scholar] [CrossRef]
- Links, M.G.; Demeke, T.; Gräfenhan, T.; Hill, J.E.; Hemmingsen, S.M.; Dumonceaux, T.J. Simultaneous profiling of seed-associated bacteria and fungi reveals antagonistic interactions between microorganisms within a shared epiphytic microbiome on Triticum and Brassica seeds. New Phytol. 2014, 202, 542–553. [Google Scholar] [CrossRef]
- Cherif-Silini, H.; Thissera, B.; Bouket, A.C.; Saadaoui, N.; Silini, A.; Eshelli, M.; Alenezi, F.N.; Vallat, A.; Luptakova, L.; Yahiaoui, B.; et al. Durum wheat stress tolerance induced by endophyte Pantoea agglomerans with genes contributing to plant functions and secondary metabolite arsenal. Int. J. Mol. Sci. 2019, 20, 3989. [Google Scholar] [CrossRef]
- Dutkiewicz, J.; Mackiewicz, B.; Lemieszek, M.K.; Golec, M.; Milanowski, J. Pantoea agglomerans: A mysterious bacterium of evil and good. Part IV. beneficial effects. Ann. Agric. Environ. Med. 2016, 23, 206–222. [Google Scholar] [CrossRef]
- Jiang, L.; Jeong, J.C.; Lee, J.-S.; Park, J.M.; Yang, J.-W.; Lee, M.H.; Choi, S.H.; Kim, C.Y.; Kim, D.-H.; Kim, S.W.; et al. Potential of Pantoea dispersa as an effective biocontrol agent for black rot in sweet potato. Sci. Rep. 2019, 9, 16354. [Google Scholar] [CrossRef]
- Brady, C.; Cleenwerck, I.; Venter, S.; Coutinho, T.; De Vos, P. Taxonomic evaluation of the genus Enterobacter based on multilocus sequence analysis (MLSA): Proposal to reclassify E. Nimipressuralis and E. Amnigenus into Lelliottia gen. nov. as Lelliottia nimipressuralis comb. nov. and Lelliottia amnigena comb. nov., respectively, E. gergoviae and E. pyrinus into Pluralibacter gen. nov. as Pluralibacter gergoviae comb. nov. and Pluralibacter pyrinus comb. nov., respectively, E. cowanii, E. radicincitans, E. oryzae and E. arachidis into Kosakonia gen. nov. as Kosakonia cowanii comb. nov., Kosakonia radicincitans comb. nov., Kosakonia oryzae comb. nov. and Kosakonia arachidis comb. nov., respectively, and E. turicensis, E. helveticus and E. pulveris into Cronobacter as Cronobacter zurichensis nom. nov., Cronobacter helveticus comb. nov. and Cronobacter pulveris comb. nov., respectively, and emended description of the genera Enterobacter and Cronobacter. Syst. Appl. Microbiol. 2013, 36, 309–319. [Google Scholar] [CrossRef]
- Witzel, K.; Gwinn-Giglio, M.; Nadendla, S.; Shefchek, K.; Ruppel, S. Genome sequence of Enterobacter radicincitans DSM16656T, a plant growth-promoting endophyte. J. Bacteriol. 2012, 194, 5469. [Google Scholar] [CrossRef]
- Remus, R.; Ruppel, S.; Jacob, H.-J.; Hecht-Buchholz, C.; Merbach, W. Colonization behaviour of two enterobacterial strains on cereals. Biol. Fertil. Soils 2000, 30, 550–557. [Google Scholar] [CrossRef]
- Becker, M.; Patz, S.; Becker, Y.; Berger, B.; Drungowski, M.; Bunk, B.; Overmann, J.; Spröer, C.; Reetz, J.; Tchuisseu Tchakounte, G.V.; et al. Comparative genomics reveal a flagellar system, a type VI secretion system and plant growth-promoting gene clusters unique to the endophytic bacterium Kosakonia radicincitans. Front. Microbiol. 2018, 9, 1997. [Google Scholar] [CrossRef]
- Berger, B.; Wiesner, M.; Brock, A.K.; Schreiner, M.; Ruppel, S.K. radicincitans, a beneficial bacteria that promotes radish growth under field conditions. Agron. Sustain. Dev. 2015, 35, 1521–1528. [Google Scholar] [CrossRef]
- Kleingesinds, C.K.B.; de Santi Ferrara, F.I.; Floh, E.L.S.; Aldar, M.P.M.; Barbosa, H.R. Sugarcane growth promotion by Kosakonia sp. ICB117 an endophytic and diazotrophic bacterium. Afr. J. Microbiol. Res. 2018, 12, 105–114. [Google Scholar] [CrossRef][Green Version]
- Scholz-Seidel, C.; Ruppel, S. Nitrogenase- and phytohormone activities of Pantoea agglomerans in culture and their reflection in combination with wheat plants. Zent. Mikrobiol. 1992, 147, 319–328. [Google Scholar] [CrossRef]
- Verma, P.; Yadav, A.N.; Kazy, S.K.; Saxena, A.K.; Suman, A. Evaluating the diversity and phylogeny of plant growth promoting bacteria associated with wheat (Triticum aestivum) growing in central zone of India. Int. J. Curr. Microbiol. Appl. Sci. 2014, 3, 432–447. [Google Scholar]
- Wendel, S.O.; Menon, S.; Alshetaiwi, H.; Shrestha, T.B.; Chlebanowski, L.; Hsu, W.-W.; Bossmann, S.H.; Narayanan, S.; Troyer, D.L. Cell based drug delivery: Micrococcus luteus loaded neutrophils as chlorhexidine delivery vehicles in a mouse model of liver abscesses in cattle. PLoS ONE 2015, 10, e0128144. [Google Scholar] [CrossRef] [PubMed]
- Sangthong, C.; Setkit, K.; Prapagdee, B. Improvement of cadmium phytoremediation after soil inoculation with a cadmium-resistant Micrococcus sp. Environ. Sci. Pollut. Res. 2016, 23, 756–764. [Google Scholar] [CrossRef]
- Prapagdee, B.; Chanprasert, M.; Mongkolsuk, S. Bioaugmentation with cadmium-resistant plant growth-promoting rhizobacteria to assist cadmium phytoextraction by Helianthus annuus. Chemosphere 2013, 92, 659–666. [Google Scholar] [CrossRef]
- Raza, A.; Faisal, M. Growth promotion of maize by desiccation tolerant Micrococcus luteus-chp37 isolated from Cholistan desert, Pakistan. Austr. J. Crop Sci. 2013, 7, 1693–1698. [Google Scholar] [CrossRef]
- Dastager, S.G.; Deepa, C.K.; Pandey, A. Isolation and characterization of novel plant growth promoting Micrococcus sp. NII-0909 and its interaction with cowpea. Plant Physiol. Biochem. 2010, 48, 987–992. [Google Scholar] [CrossRef]
- Khan, A.L.; Waqas, M.; Kang, S.-M.; Al-Harrasi, A.; Hussain, J.; Al-Rawahi, A.; Al-Khiziri, S.; Ullah, I.; Ali, L.; Jung, H.-Y.; et al. Bacterial endophyte Sphingomonas sp. LK11 produces gibberellins and IAA and promotes tomato plant growth. J. Microbiol. 2014, 52, 689–695. [Google Scholar] [CrossRef]
- Asaf, S.; Khan, M.A.; Khan, A.L.; Waqas, M.; Shahzad, R.; Kim, A.-Y.; Kang, S.-M.; Lee, I.-J. Bacterial endophytes from arid land plants regulate endogenous hormone content and promote growth in crop plants: An example of Sphingomonas sp. and Serratia marcescens. J. Plant Interact. 2017, 12, 31–38. [Google Scholar] [CrossRef]
- Cheng, C.; Wang, R.; Sun, L.; He, L.; Sheng, X. Cadmium-resistant and arginine decarboxylase-producing endophytic Sphingomonas sp. C40 decreases cadmium accumulation in host rice (Oryza sativa Cliangyou 513). Chemosphere 2021, 275, 130109. [Google Scholar] [CrossRef]
- Yu, R.-Q.; Kurt, Z.; He, F.; Spain, J.C. Biodegradation of the allelopathic chemical pterostilbene by a Sphingobium sp. strain from the peanut rhizosphere. Appl. Environ. Microbiol. 2018, 85, e02154-18. [Google Scholar] [CrossRef]
- Wanees, A.E.; Zaslow, S.J.; Potter, S.J.; Hsieh, B.P.; Boss, B.L.; Izquierdo, J.A. Draft genome sequence of the plant growth-promoting Sphingobium sp. strain AEW4, isolated from the rhizosphere of the beachgrass Ammophila breviligulata. Genome Announc. 2018, 6, e00410-18. [Google Scholar] [CrossRef]
- Young, C.-C.; Arun, A.B.; Kampfer, P.; Busse, H.-J.; Lai, W.-A.; Chen, W.-M.; Shen, F.-T.; Rekha, P.D. Sphingobium rhizovicinum sp. nov., isolated from rhizosphere soil of Fortunella hindsii (Champ. ex Benth.) Swingle. Int. J. Syst. Evol. Microbiol. 2008, 58, 1801–1806. [Google Scholar] [CrossRef]
- Peiffer, J.A.; Spor, A.; Koren, O.; Jin, Z.; Tringe, S.G.; Dangl, J.L.; Buckler, E.S.; Ley, R.E. Diversity and heritability of the maize rhizosphere microbiome under field conditions. Proc. Natl. Acad. Sci. USA 2013, 110, 6548–6553. [Google Scholar] [CrossRef]
- Kim, H.; Nishiyama, M.; Kunito, T.; Senoo, K.; Kawahara, K.; Murakami, K.; Oyaizu, H. High population of Sphingomonas species on plant surface. J. Appl. Microbiol. 1998, 85, 731–736. [Google Scholar] [CrossRef]
- Luo, Y.; Wang, F.; Huang, Y.; Zhou, M.; Gao, J.; Yan, T.; Sheng, H.; An, L. Sphingomonas sp. Cra20 increases plant growth rate and alters rhizosphere microbial community structure of Arabidopsis thaliana under drought stress. Front. Microbiol. 2019, 10, 1221. [Google Scholar] [CrossRef]
- Priya, D.A.; Kalaiselvi, T. Evaluating the effect of Sphingobium yanoikuyae MH394206 and mixed consortia on growth of rice CO 51 in moisture deficit condition. J. Pharmacogn. Phytochem. 2020, 9, 2016–2021. [Google Scholar] [CrossRef]
- Agnolucci, M.; Palla, M.; Cristani, C.; Cavallo, N.; Giovannetti, M.; De Angelis, M.; Gobbetti, M.; Minervini, F. Beneficial plant microorganisms affect the endophytic bacterial communities of durum wheat roots as detected by different molecular approaches. Front. Microbiol. 2019, 10, 2500. [Google Scholar] [CrossRef]
- Xu, J.; Kloepper, J.W.; Huang, P.; McInroy, J.A.; Hu, C.H. Isolation and characterization of N2-fixing bacteria from giant reed and switchgrass for plant growth promotion and nutrient uptake. J. Basic. Microbiol. 2018, 58, 459–471. [Google Scholar] [CrossRef]
- Lane, D.J. 16S/23S rRNA Sequencing. In Nucleic Acid Techniques in Bacterial Systematic; Stackebrandt, E., Goodfellow, M., Eds.; John Wiley and Sons: New York, NY, USA, 1991; pp. 115–175. [Google Scholar]
- Turner, S.; Pryer, K.M.; Miao, V.P.W.; Palmer, J.D. Investigating deep phylogenetic relationships among cyanobacteria and plastids by small subunit rRNA sequence analysis. J. Eukaryotic Microbiol. 1999, 46, 327–338. [Google Scholar] [CrossRef]




| pH | Content of Organic Matter (g∙kg−1) | Micronutrients (ppm) | ||
|---|---|---|---|---|
| Zn | Fe | Cu | ||
| 7.15 ± 0.02 | 74.59 ± 1.89 | 1.69 ± 0.21 (1.22–4.44) | 12.46 ± 1.01 (8.23–18.29) | 0.42 ± 0.05 (0.20–0.91) |
| Isolation Source | All Isolates from the Studied Material | Colour of the Isolates | Number of Isolates Used for the Identification | Identity | Gram Staining |
|---|---|---|---|---|---|
| Oksamyt myronivs’kyi grain U.MO | 11 | Yellow Yellow | U.MO1 | + | + |
| White White White | U.MO2 | + | - | ||
| Beige Beige | U.MO3 | + | - | ||
| Yellow-beige Yellow-beige | U.MO4 | - | |||
| Yellow Yellow | U.MO5 | - | |||
| Struna myronivs’ka grain U.SM | 11 | Yellow-cream Yellow-cream Yellow-cream | U.SM1 | + | - |
| Beige-pink | U.SM2 | + | + | ||
| Yellow Yellow Yellow Yellow Yellow | U.SM3 | + | + | ||
| Beige Beige | U.SM4 | - | |||
| Dubravka grain U.D | 8 | Yellow-cream Yellow-cream | U.D1 | + | + |
| Yellow-beige Yellow-beige Yellow-beige | U.D2 | + | + | ||
| Yellow Yellow | U.D3 | - | |||
| Beige | U.D4 | + | + | ||
| Holikovs’ka grain U.H | 4 | Beige | U.H1 | + | + |
| Yellow | U.H2 | + | + | ||
| Yellow-cream Yellow-cream | U.H3 | + | - |
| Isolation Source | Bacterial Genus | Culture Collection ID | GenBank Accession Number |
|---|---|---|---|
| Oksamyt myronivs’kyi grain | Staphylococcus | U.MO1 | MT302199 |
| Pantoea | U.MO2 | MT302200 | |
| Pantoea | U.MO3 | MT302201 | |
| Struna myronivs’ka grain | Kosakonia | U.SM1 | MT302202 |
| Micrococcus | U.SM2 | MT302203 | |
| Staphylococcus | U.SM3 | MT302204 | |
| Dubravka grain | Bacillus | U.D1 | MT302194 |
| Staphylococcus | U.D2 | MT302195 | |
| Sphingobium | U.D4 | MT302196 | |
| Holikovs’ka grain | Staphylococcus | U.H1 | MT302197 |
| Bacillus | U.H2 | MT312840 | |
| Sphingobium | U.H3 | MT302198 |
| Wheat Variety | Number of Grains Per Spike (GPS) | Spike Height (SH) (mm) | Thousand-Grain Weight (TGW) (g) | Grain Yield (GY) (qt∙ha−1) |
|---|---|---|---|---|
| Oksamyt myronivs’kyi | 32.52 AB ± 1.21 | 88.81 ABC ± 3.41 | 40.01 A ± 1.85 | 63.26 a ± 3.84 |
| Struna myronivs’ka | 35.77 A ± 1.04 | 85.84 AB ± 3.55 | 37.83 AB ± 0.92 | 59.14 a ± 3.21 |
| Dubravka | 35.62 A ± 1.93 | 78.93 AC ± 2.53 | 37.46 AB ± 1.05 | 60.66 a ± 2.12 |
| Holikovs’ka | 29.57 B ± 0.94 | 58.02 D ± 1.34 | 33.29 B ± 1.18 | 34.64 b ± 3.54 |
| Parameters | PC1 | PC2 | PC3 |
|---|---|---|---|
| GPS | 0.72112 | −0.55793 | 0.41075 |
| TGW | 0.93699 | −0.092344 | −0.33693 |
| GY | 0.97985 | −0.19252 | −0.053142 |
| Fe | 0.44635 | 0.89224 | 0.06846 |
| Cu | 0.46273 | 0.87517 | 0.14126 |
| Zn | −0.99163 | 0.12679 | 0.024547 |
| Loadings | |||
| Eigenvalue | 3.75474 | 1.93496 | 0.310304 |
| Percentage variance | 0.62579 | 0.32249 | 0.051717 |
Publisher’s Note: MDPI stays neutral with regard to jurisdictional claims in published maps and institutional affiliations. |
© 2021 by the authors. Licensee MDPI, Basel, Switzerland. This article is an open access article distributed under the terms and conditions of the Creative Commons Attribution (CC BY) license (https://creativecommons.org/licenses/by/4.0/).
Share and Cite
Makar, O.; Kuźniar, A.; Patsula, O.; Kavulych, Y.; Kozlovskyy, V.; Wolińska, A.; Skórzyńska-Polit, E.; Vatamaniuk, O.; Terek, O.; Romanyuk, N. Bacterial Endophytes of Spring Wheat Grains and the Potential to Acquire Fe, Cu, and Zn under Their Low Soil Bioavailability. Biology 2021, 10, 409. https://doi.org/10.3390/biology10050409
Makar O, Kuźniar A, Patsula O, Kavulych Y, Kozlovskyy V, Wolińska A, Skórzyńska-Polit E, Vatamaniuk O, Terek O, Romanyuk N. Bacterial Endophytes of Spring Wheat Grains and the Potential to Acquire Fe, Cu, and Zn under Their Low Soil Bioavailability. Biology. 2021; 10(5):409. https://doi.org/10.3390/biology10050409
Chicago/Turabian StyleMakar, Orysia, Agnieszka Kuźniar, Ostap Patsula, Yana Kavulych, Volodymyr Kozlovskyy, Agnieszka Wolińska, Ewa Skórzyńska-Polit, Olena Vatamaniuk, Olga Terek, and Nataliya Romanyuk. 2021. "Bacterial Endophytes of Spring Wheat Grains and the Potential to Acquire Fe, Cu, and Zn under Their Low Soil Bioavailability" Biology 10, no. 5: 409. https://doi.org/10.3390/biology10050409
APA StyleMakar, O., Kuźniar, A., Patsula, O., Kavulych, Y., Kozlovskyy, V., Wolińska, A., Skórzyńska-Polit, E., Vatamaniuk, O., Terek, O., & Romanyuk, N. (2021). Bacterial Endophytes of Spring Wheat Grains and the Potential to Acquire Fe, Cu, and Zn under Their Low Soil Bioavailability. Biology, 10(5), 409. https://doi.org/10.3390/biology10050409









